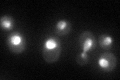
YDL111C
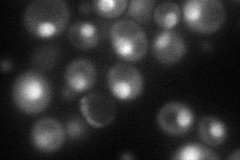
YDL111C
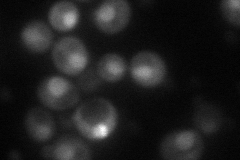
YDL111C
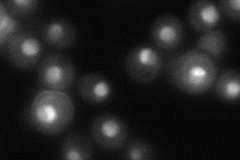
YDL111C
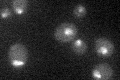
YDL111C

View description
Exosome non-catalytic core component; involved in 3'-5' RNA processing and degradation in both the nucleus and the cytoplasm; has similarity to E. coli RNase PH and to human hRrp42p (EXOSC7)
Localization:
Intensity:
Fold change:
Significance:
-
C’ GFP library in SD
nucleus52.94 -
N' NOP1pr-GFP in SD
nucleolus80.0338 -
N' TEF2pr-mCherry in SD
nucleus54.4494 -
N' NATIVEpr-GFP in SD
nucleus,nucleolus51.0812 -
N' TEF2pr-VC and Cyto-VN in SD

cytosol31.8679 -
C’ GFP library in SD+DTT

nucleus39.140.73No -
C’ GFP library in SD+H2O2

nucleus51.050.96No -
C’ GFP library in Starvation Media
nucleus24.810.46Yes -
C’ GFP library on the background of Pup2-DaMP

nucleus -
C’ GFP library on the background of CCT mutant

nucleus50.80810.959679No
